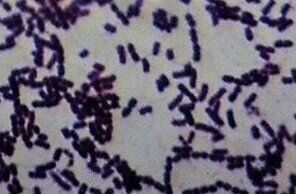
病原体であるコリネバクテリウム属菌（写真提供／斉藤動物病院院長　齊藤邦史先生）

犬も人も気を付けたい、危険な「ズーノーシス」
 噛まれたり引っかかれたりすることでも感染する
噛まれたり引っかかれたりすることでも感染する
ズーノーシス(人獣共通感染症)は、人から犬へ、犬から人へもうつる疾病・感染症のこと。病原体や症状は病気によってさまざまですが、なかには感染するとほぼ100%死にいたり、今年2020年にも死亡例が出ているウイルスもあります。
新型コロナウイルスのために感染予防の意識が高まっている昨今ではありますが、危険なズーノーシスを5つ、ご紹介します。
死亡率ほぼ100%!「狂犬病」
 すべての哺乳類に感染する(写真提供:CDC's Public Health Image Library)
すべての哺乳類に感染する(写真提供:CDC's Public Health Image Library)
狂犬病は、名の通り「狂犬病ウイルス」を病原体とする病気のことで、おもに海外で発症した犬・猫・アライグマ・キツネ・コウモリなどに噛まれることで感染します。感染した動物に噛まれるなどで、その唾液が体内に侵入すると、1~3カ月の潜伏期間のあとに発症。発熱や食欲不振など風邪に似た症状に始まり、不安感や錯乱などの精神症状があらわれます。発症から数日後には呼吸障害でほぼ100%死に至ります。
1957年を最後に、人も動物も日本国内での感染はありませんが、1970年にネパール、2006年と2020年にフィリピンで犬に噛まれて感染し、日本に入国後に発症・死亡した輸入感染の例が報告されています。
敗血症など重篤例も!「カプノサイトファーガ感染症」
カプノサイトファーガ感染症の病原体は細菌で、犬や猫などの病原体をもつ動物に噛まれたり、ひっかかれたりした傷口から感染します。傷口をなめられて感染することもあります。これらの菌は犬や猫の口の中に存在する常在菌のため、犬・猫に症状が出ることはありません。しかし人に感染すると、発熱や倦怠感、吐き気、筋肉痛、頭痛などから始まり、重症化すると全身の組織や臓器に障害をきたす敗血症を引き起こします。発症すると半日から1日で死亡することもあります。
日本では1997年から2017年までに人への感染が93例報告され、うち19例が死亡例となっています。93例のうち、2011年以降の症例が68例と増加していることから、注目すべき感染症として研究が進められています。
寄生虫による感染「エキノコックス症」
エキノコックス症の病原体は寄生虫で、キタキツネが生息する北海道地方では要注意の感染症です。感染源となるキタキツネのフンの中にエキノコックスの虫卵が排出され、犬がなめるなどして感染。虫の卵に触れる、虫の卵が付着した食べ物や生水(とくに汚染地域の湧水)を介して口から入ることでも感染します。
犬では軽い下痢の症状が見られる程度ですが、人では成人で約10年の潜伏期間を経て発症します。病気の進行とともに肝臓に障害が起こり、黄疸(おうだん)や腹水が見られます。病原体が肺に及ぶと肺炎に、脳に及ぶと意識障害やけいれん発作を起こします。
「コリネバクテリウム・ウルセランス感染症」
 病原体であるコリネバクテリウム属菌(写真提供/斉藤動物病院院長 齊藤邦史先生)
病原体であるコリネバクテリウム属菌(写真提供/斉藤動物病院院長 齊藤邦史先生)
感染した犬や猫との接触、飛沫などから感染します。海外では殺菌処理されていない生乳を摂取することで感染したケースも。人・犬ともにクシャミ、鼻水、発熱など風邪に似た症状に始まり、咽頭痛やセキのほか、ジフテリアと似た症状を引き起こします。重症化すると呼吸困難により死亡する例も。人から人への感染はなく、感染者の多くは高齢者であると報告されています。
マダニ由来の新しいズーノーシス「SFTF」
SFTFとは、SFTFウイルスを病原体とする重症熱性血小板減少症候群のこと。マダニによって媒介される感染症で、感染したマダニに噛まれることで感染し、発症した犬や猫の体液から感染します。2013年に日本国内で初めて報告された新しいズーノーシスのひとつで、人・犬ともに発熱や消化器症状(下痢・嘔吐・腹痛など)のほか、血小板や白血球の減少などが見られます。
予防を徹底して、感染リスクを減らそう
いかがでしたか? ズーノーシスの病原体は世界で200種類ともいわれ、ご紹介した以外にもまだまだありますが、正しい知識を身につけていれば、怖がりすぎる必要はありません。散歩のあとは、愛犬を家に入れる前にブラッシングをして汚れを落としたり、野生生物にはむやみに触らないなど、基本的な対策を心がけることで、飼い主さん自身だけでなく愛犬もズーノーシスから守ってあげてくださいね。
参考/愛犬との暮らしをもっと楽しむ『いぬのきもち』2020年10月号「犬から人にうつる人獣共通感染症 ズーノーシスってどんな病気?」(監修:獣医師 荒島康友先生)
ピクトグラム/ohmae-d
構成・文/佐藤英美、影山エマ

.jpg?w=90&h=90&resize_type=cover&resize_mode=force)
.jpg?w=90&h=90&resize_type=cover&resize_mode=force)
.jpg?w=90&h=90&resize_type=cover&resize_mode=force)
.jpg?w=90&h=90&resize_type=cover&resize_mode=force)
.jpg?w=90&h=90&resize_type=cover&resize_mode=force)


.jpg?w=90&h=90&resize_type=cover&resize_mode=force)

.jpg?w=90&h=90&resize_type=cover&resize_mode=force)